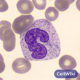
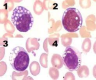
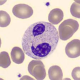
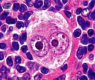
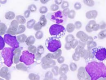

: cuerpos de Döhle
: cuerpos de Döhle
 : bastones de Auer
: bastones de Auer
: vacuolización
: vacuolización
 : síndrome de Chédiak-Higashi
: síndrome de Chédiak-Higashi
 : anomalía de Alder-Reilly
: anomalía de Alder-Reilly
: anomalía de Pelger-Hüet
: anomalía de Pelger-Hüet
 : leucemia linfática crónica
: leucemia linfática crónica
 : leucemia mieloide crónica
: leucemia mieloide crónica
: linfoma de Hodgkin
: linfoma de Hodgkin
: linfoma de No Hodgkin (Burkitt)
: linfoma de No Hodgkin (Burkitt)
Otros juegos similares:
Otros juegos similares:
Otros juegos similares:






















